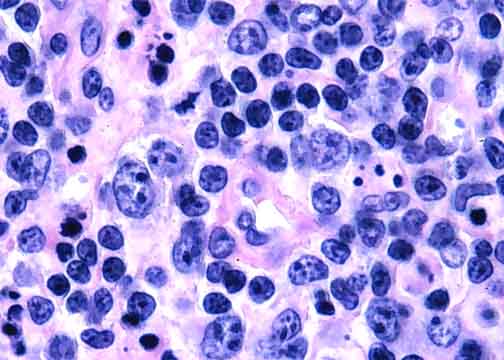

The malignant T-cells are heterogeneous in size and shape. Among the morphologic clues (not necessarily present here) that a lymphoma derives from T-cells are clear cytoplasm; a diverse benign inflammatory accompaniment including eosinophils, histiocytes, and others; and multiple small foci of necrosis. |